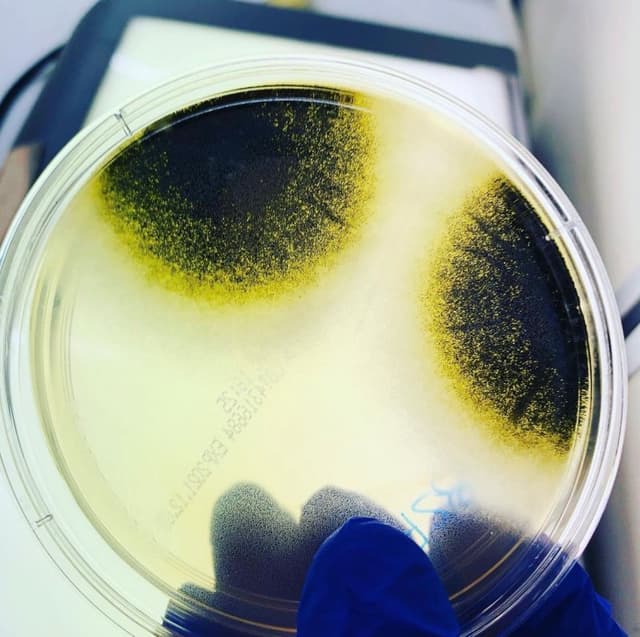
Chemica Lab - Immagine 2

Chemica Lab
Acquista online
Gestisci la tua attività su MapTap.it
Reclama Chemica Lab per accedere al pannello di gestione, rispondere alle recensioni e aggiornare le informazioni del tuo business
Descrizione
Galleria


Perché non sono visibili?
Questa attività è su un Piano Gratuito. Passa a un piano Premium per sbloccare tutti i servizi.
È la tua attività?
Orari di apertura
Servizi offerti
Perché non sono visibili?
Questa attività è su un Piano Gratuito. Passa a un piano Premium per sbloccare tutti i servizi.
È la tua attività?
Informazioni legali
Domande frequenti
Dove si trova Chemica Lab?
Chemica Lab si trova in Via Alcide De Gasperi, 38, 20035 Villa Cortese, Milano.
Quali sono gli orari di apertura di Chemica Lab?
Chemica Lab è aperto nei seguenti orari: Lunedì: 09:00-13:00, Lunedì: 14:00-18:00, Martedì: 09:00-13:00, Martedì: 14:00-18:00, Mercoledì: 09:00-13:00, Mercoledì: 14:00-18:00, Giovedì: 09:00-13:00, Giovedì: 14:00-18:00, Venerdì: 09:00-13:00, Venerdì: 14:00-18:00.
Come posso contattare Chemica Lab?
Puoi contattare Chemica Lab al telefono +39 0331 670764 o via email a chemica@libero.it.
Come raggiungere Chemica Lab?
Chemica Lab si trova in Via Alcide De Gasperi, 38, 20035 Villa Cortese, Milano. Puoi utilizzare Google Maps o Apple Maps per ottenere indicazioni stradali.
Quali servizi offre Chemica Lab?
Chemica Lab offre i seguenti servizi: Analisi delle emissioni in atmosfera, Analisi dei rifiuti, Analisi del terreno, Campionamento, Analisi emissioni fumi.
Sei il proprietario?
Reclama questa attività per gestire il tuo profilo e ricevere recensioni
Informazioni rapide
Attività simili nelle vicinanze
Azeta - Derattizzazione | Disinfestazione | Disinfezione e Sanificazione
Azeta, opera nel settore dell’igiene ambientale, grazie all'esperienza del titolare Torrielli Pierluigi, acquisita per merito dei suoi studi e per mezzo dei continui aggiornamenti. Torrielli ed i suoi tecnici hanno partecipato e continuano a partecipare, a conferenze, svolte in Italia, sui temi inerenti i servizi di profilassi e igiene ambientale, organizzate da ditte produttrici e fornitrici di prodotti. L'impresa è specializzata in procedure H.A.C.C.P. D.L. n.193 per aziende alimentari, ristoranti, mense, comunità, negozi, macelli, riserie ecc. Inoltre, opera, in ottemperanza alle vigenti leggi (n. 81), anche nei settori non alimentare (industrie, condomini, abitazioni ecc.). Distruzione radicale di topi, blatte, scarafaggi, mosche, zanzare, vespe, pulci, formiche, calabroni, zecche, ragni, insetti striscianti, ecc.
C.T.M. Ambiente
Grazie alla competenza maturata nel corso degli anni, C.T.M. Ambiente si distingue per l’alta qualità dei suoi prodotti e servizi, garantendo soluzioni personalizzate per rispondere alle esigenze specifiche di ogni cliente. L’azienda collabora con professionisti altamente qualificati e utilizza tecnologie all’avanguardia per progettare e realizzare impianti di insonorizzazione su misura, assicurando un impatto ambientale minimo e massimizzando l’efficienza operativa.
Garau Francesca SORGENTA
So-What Srl Società Benefit
So-What è una società benefit che si occupa di consulenza in ambito Sostenibilità e ESG. >> info@so-what.it
Studio Chimico Professionale
Lo Studio offre servizi di consulenza tecnica e gestionale in: anlisi chimiche, gestione dei rifiuti, pratiche albo Gestori, schede di sicurezza, consulenza ADR
Studio S.E.I.
Studio S.E.I. S.r.l. con l’obiettivo di offrire servizi di consulenza ed analisi commisurati alle reali esigenze del cliente in materia di ambiente, sicurezza e qualità.L’ambiente costituisce oggi una realtà sempre evidente e l’inquinamento rappresenta uno dei problemi più importanti da affrontare.Per limitare la diffusione di tale fenomeno la normativa ambientale è sempre in costante aggiornamento e sono sempre più numerosi e severi i controlli analitici richiesti.La nostra pluriennale esperienza in questo settore è una garanzia della precisione con la quale operiamo e della serietà che offriamo.Sempre più aziende, nel corso degli anni, hanno scelto la nostra società come Partner per la gestione delle problematiche ecologiche, come Laboratorio di fiducia per analisi chimiche, come Consulente per importanti e pratici consigli o come Società per una completa e programmata assistenza tecnico-analitica degli adempimenti in materia ambientale.